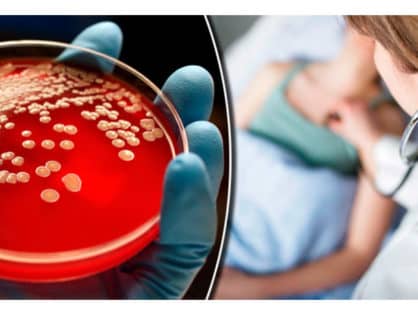

- Ліки від стафілококу: що варто знати?
- Що таке стафілокок?
- Основні симптоми стафілококових інфекцій
- Місцеві ліки від стафілококу: коли вони потрібні?
- Популярні місцеві засоби
- Антибіотики для боротьби із стафілококами: коли без них ніяк?
- Коли варто звернутись до антибіотиків?
- Альтернативні методи лікування: народні засоби і дієта
- Що можна спробувати?
- Що робити, якщо інфекція не відступає?
Ліки від стафілококу: що варто знати?
Зіткнувшись із стафілококовою інфекцією, більшість людей одразу шукають ліки від стафілококу. Це природна реакція, адже захворювання пов’язане з неприємними симптомами і потенційними ускладненнями. Насправді, вирішення проблеми не завжди лежить на поверхні. Необхідно знати про різноманіття підходів до лікування та правильно підібрати медикаменти чи методи.
Що таке стафілокок?
І ось, стафілококи — мікроби, які можуть викликати безліч захворювань. Маленькі, але злісні. Вони здатні викликати як легкі шкірні інфекції, так і серйозні захворювання, які вимагають госпіталізації. Перелік можливих симптомів довгий і нудний, тому краще перейти до найважливішого.
Основні симптоми стафілококових інфекцій
- Гнійники та нарости на шкірі
- Почервоніння і біль у місці інфекції
- Лихоманка та загальне нездужання
- У разі тяжких форм — ураження внутрішніх органів
Місцеві ліки від стафілококу: коли вони потрібні?
Якщо у вас легка форма шкірної інфекції, може допомогти місцеве лікування. Іноді достатньо обійтися антибактеріальними мазями або кремами. При трошки гіршому стані може знадобитись і щось суттєвіше. Стафілококи, вони такі, легкими не бувають завжди.
Популярні місцеві засоби
| Назва препарату | Форма | Особливості |
|---|---|---|
| Бактробан | Мазь | Знищує бактерії на поверхні шкіри |
| Фуцидин | Крем | Ефективний проти стафілококів, але має свої побічки |
Антибіотики для боротьби із стафілококами: коли без них ніяк?
Часом стафілокок вміє так загострити ситуацію, що місцевих засобів не вистачає. І ось тоді на сцену виходять антибіотики. Їх підбирають строго індивідуально. Ніякої самодіяльності, лише рекомендований курс.
Коли варто звернутись до антибіотиків?
- У разі поширеної інфекції
- Якщо є ризик ускладнень
- При рецидивах та хронічних формах захворювання
Чесно, сам приймав ці таблетки. Щоправда, смаку не відчув, але головне, що вони працюють.
Альтернативні методи лікування: народні засоби і дієта
Чи пробували ви коли-небудь звертатись до бабусиних рецептів? Деякі люди підряджують народну медицину, аби допомогти організму в боротьбі з інфекцією.
Що можна спробувати?
- Часник: Вірять, що він має антибактеріальні властивості. Чи це правда — спитайте у стафілокока, але кажуть, що допомагає.
- Мед акації: Натуральний антисептик, який іноді навіть класифікують як супергероя серед продуктів харчування.
- Чай з екстрактом ехінацеї: Запарте на здоров’я, кажуть, він може зміцнити імунітет.
Ці методи не варто розглядати як повноцінну заміну традиційній медицині. Але часом вони можуть доповнити основну терапію й зробити боротьбу трохи ефективнішою.
Що робити, якщо інфекція не відступає?
Інколи здається, що боротися зі стафілококами — це як із вітряками. Тут важливо не впадати в паніку, а звернутися за консультацією до фахівця. Лікар може призначити додаткову діагностику або перейматися переглядом лікування.
Зрештою, маємо справу з підступними бактеріями. Однак важливо пам’ятати, що більшість інфекцій піддаються лікуванню за умови правильного підходу та своїх крихітних секретів.